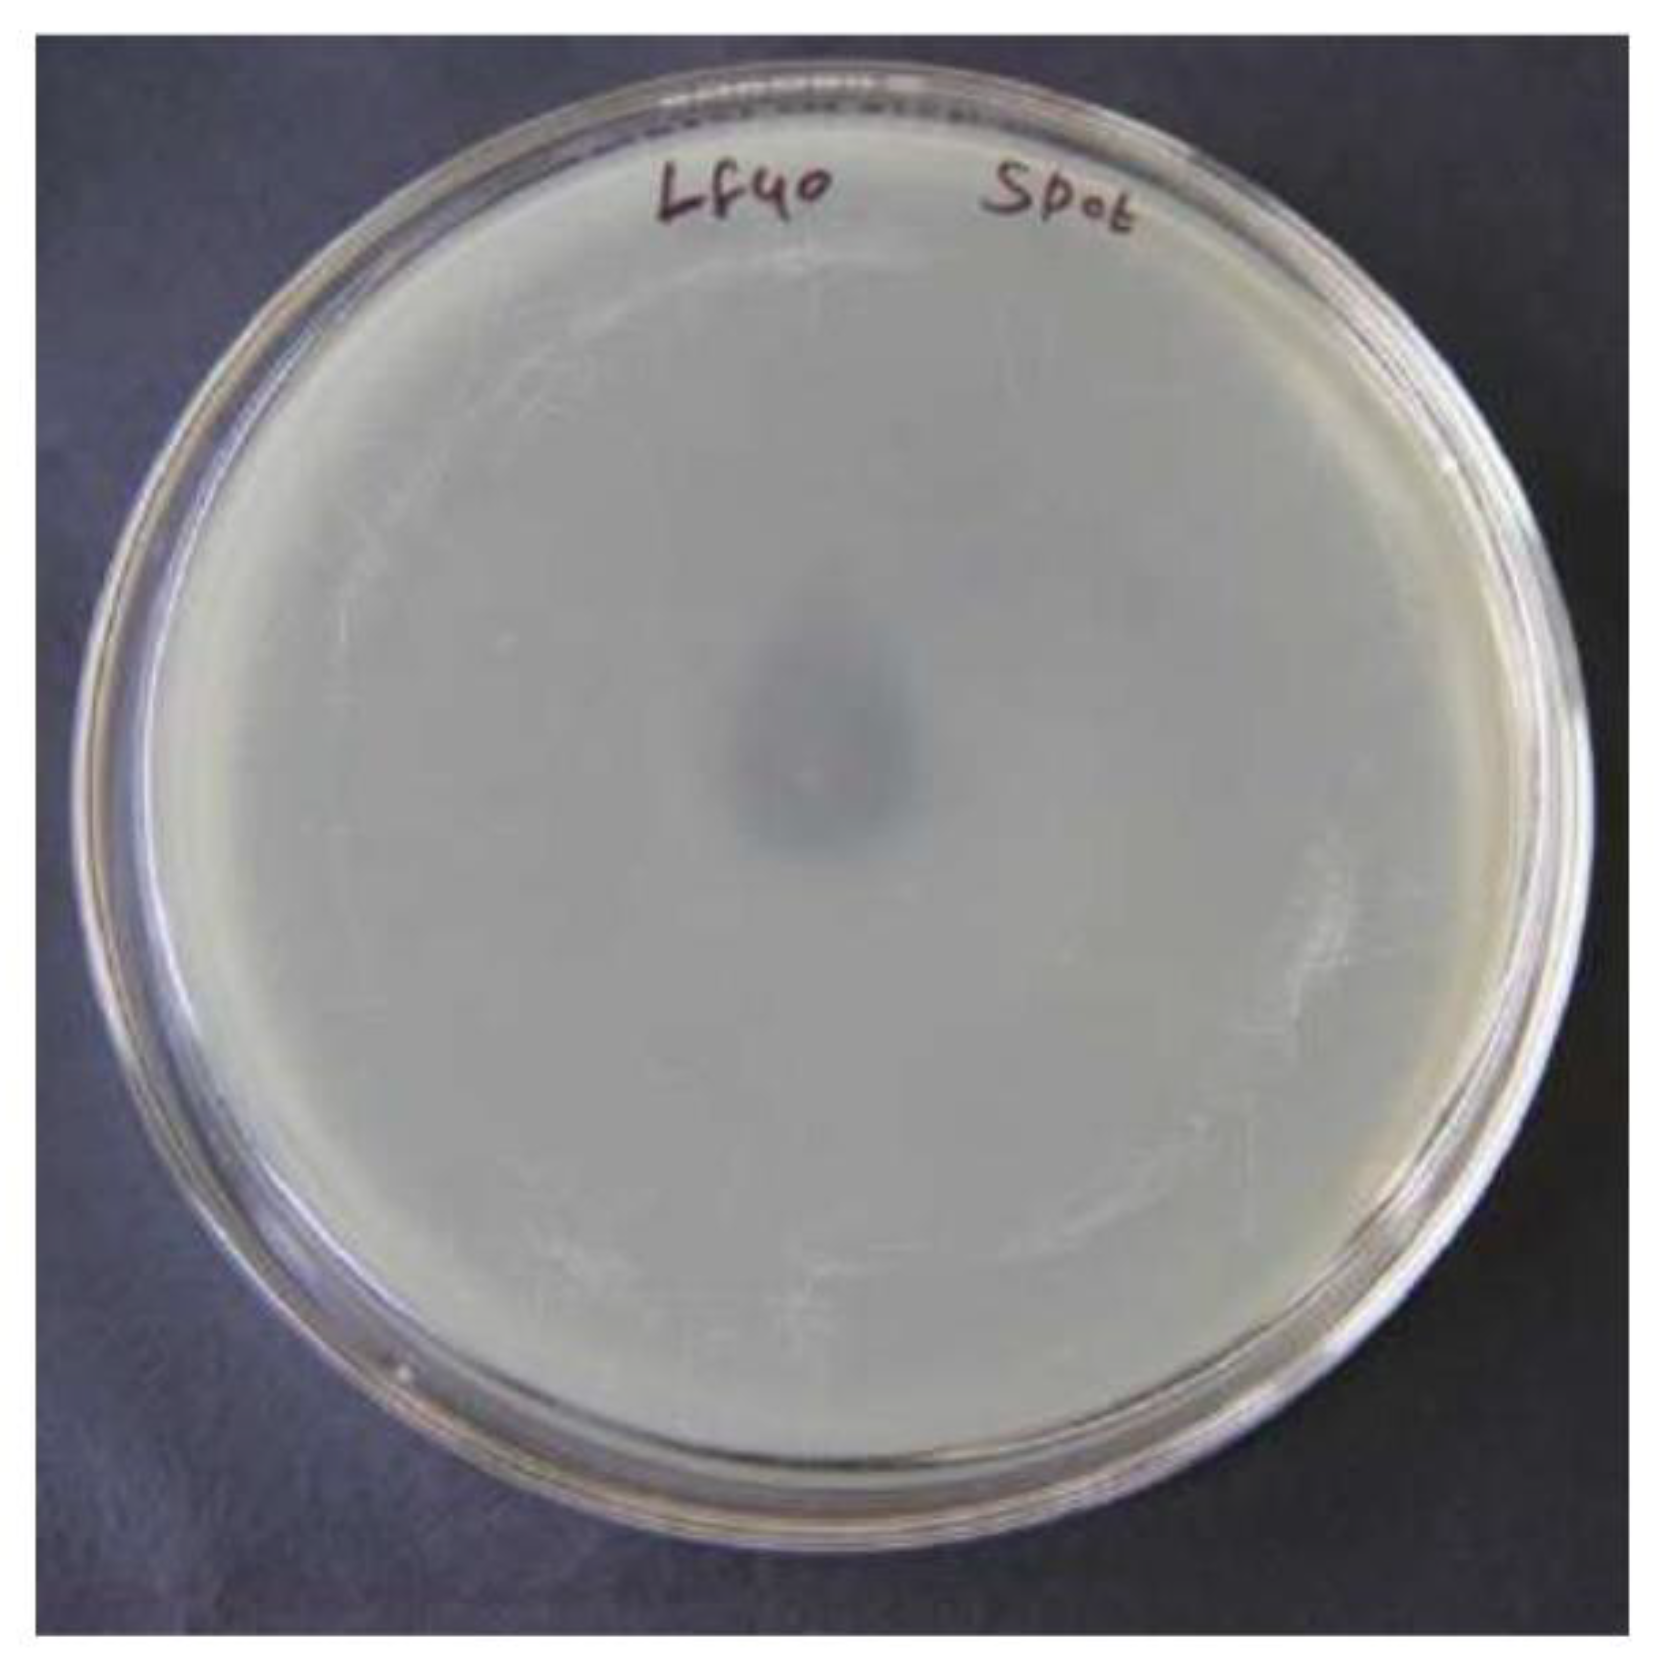
Preprints 83301 g006

Submitted:
25 August 2023
Posted:
31 August 2023
Read the latest preprint version here
Abstract
Keywords:
Introduction
Materials and methods
Bacterial cultures
Samples
Clearance test
Double layer plaque assay
Spot test with Mitomycin induction to detect temperate phages
Electron Microscopic studies
Result and Discussion
Screening and Isolation of bacteriophages
Clearance tests



Double layer plaque assay
Induction of phage with mitomycin

Spot test
Electron microscopic studies
Conclusion
References
- del, B.; Cruz, M.; Ladero, V.; Martínez, N. ; M., D.; Fernndez, M.; A., M. Bacteriophages in Dairy Industry: PCR Methods as Valuable Tools. Bacteriophages. [CrossRef]
- Canchaya, C.; Proux, C.; Fournous, G.; Bruttin, A.; Brüssow, H. Prophage Genomics. Microbiol. Mol. Biol. Rev. 2003, 67, 238–276. [Google Scholar] [CrossRef] [PubMed]
- Farenc, C.; Spinelli, S.; Vinogradov, E.; Tremblay, D.; Blangy, S.; Sadovskaya, I.; Moineau, S.; Cambillau, C. Molecular Insights on the Recognition of a Lactococcus lactis Cell Wall Pellicle by the Phage 1358 Receptor Binding Protein. J. Virol. 2014, 88, 7005–7015. [Google Scholar] [CrossRef] [PubMed]
- Lillehaug, D. An improved plaque assay for poor plaque-producing temperate lactococcal bacteriophages. J. Appl. Microbiol. 1997, 83, 85–90. [Google Scholar] [CrossRef] [PubMed]
- Dairy reporter, (2016). Yogurt market can hit $1bn by 2021 in India: Report.
- Davidson BE, Powell IB, Hillier AJ. Temperate bacteriophages and lysogeny in lactic acid bacteria. (). FEMS Microbiol Rev. 1990, 7, 79–90.
- E. Jończyk, M. Kłak, R. Międzybrodzki, and A. Górski. The influence of external factors on bacteriophages—review Folia Microbiol (Praha). May; 2011, 56, 191–200.
- Emond E, Moineau S. Bacteriophages and food fermentations. In: McGrath S, van Sinderen D, eds. (2007). Bacteriophage: Genetics and Molecular Biology. Horizon Scientific Press/Caister Academic Press 2007; 93-124.
- Global agricultural information network,( 2015). USDA Foreign agricultural service. GAIN report number: IN5125 dated 30.09.2015.
- Jarvis, A. Bacteriophages of Lactic Acid Bacteria. J. Dairy Sci. 1989, 72, 3406–3428. [Google Scholar] [CrossRef]
- Khakhria R, Duck D, Lior H (). Extended phage-typing scheme for Escherichia coli O157:H7.. Dec; 1990, 105, 511–20.
- Mullan, W.M.A.; Plaque formation. [On-line]. 2002. Available online: https://www.dairyscience.info/index.php/enumeration-of-lactococcal-bacteriophages/plaque-formation.html (accessed on 14 June 2016).
- Muyad M., M. (2009). Molecular identification of Pseudomonas auroginosa and its phage effect on those bacterial strain.
- Plessas, S.; Alexopoulos, A.; Voidarou, C.; Stavropoulou, E.; Bezirtzoglou, E. Microbial ecology and quality assurance in food fermentation systems. The case of kefir grains application. Anaerobe 2011, 17, 483–485. [Google Scholar] [CrossRef] [PubMed]
- Santos, S.B.; Carvalho, C.M.; Sillankorva, S.; Nicolau, A.; Ferreira, E.C.; Azeredo, J. The use of antibiotics to improve phage detection and enumeration by the double-layer agar technique. BMC Microbiol. 2009, 9, 148–148. [Google Scholar] [CrossRef] [PubMed]
- Whitehead and Huntera1 Starter cultures for cheese manufacture: Further attempts to eliminate failures due to bacteriophage. J. Dairy Res. 2009, 12, 63–70.
- Suárez, V.; Zago, M.; Quiberoni, A.; Carminati, D.; Giraffa, G.; Reinheimer, J. Lysogeny inLactobacillus delbrueckiistrains and characterization of two new temperate prolate-headed bacteriophages. J. Appl. Microbiol. 2008, 105, 1402–1411. [Google Scholar] [CrossRef] [PubMed]
- Suárez, V.B.; Quiberoni, A.; Binetti, A.G.; Reinheimer, J.A.; Suárez, A.Q.V.B. Thermophilic Lactic Acid Bacteria Phages Isolated from Argentinian Dairy Industries. J. Food Prot. 2002, 65, 1597–1604. [Google Scholar] [CrossRef] [PubMed]
- Svenson, U. , and A. Christiansson.( 1991). Methods for phage monitoring. Bull. FIL-IDF 263(4): 29-39.
- Tammelin, A. Staphylococus aureus surgical wound infection; possibility of preventing wound infection by use of bacteriophages. Nature 1992, 22, 26–31. [Google Scholar]
- Shiby, V.K.; Mishra, H.N. Fermented Milks and Milk Products as Functional Foods—A Review. Crit. Rev. Food Sci. Nutr. 2013, 53, 482–496. [Google Scholar] [CrossRef] [PubMed]
- Ventura, M.; Zomer, A.; Canchaya, C.; O'Connell-Motherway, M.; Kuipers, O.; Turroni, F.; Ribbera, A.; Foroni, E.; Buist, G.; Wegmann, U.; et al. Comparative Analyses of Prophage-Like Elements Present in Two Lactococcus lactis Strains. Appl. Environ. Microbiol. 2007, 73, 7771–7780. [Google Scholar] [CrossRef] [PubMed]
- Whitehead, H.R. Bacteriophage in cheese manufacture. Bacteriol.Rev. 1953, 17, 109–123. [Google Scholar] [CrossRef] [PubMed]
- Zhang, X.; Kong, J.; Qu, Y. Isolation and characterization of a Lactobacillus fermentum temperate bacteriophage from Chinese yogurt. J. Appl. Microbiol. 2006, 101, 857–863. [Google Scholar] [CrossRef] [PubMed]
Disclaimer/Publisher’s Note: The statements, opinions and data contained in all publications are solely those of the individual author(s) and contributor(s) and not of MDPI and/or the editor(s). MDPI and/or the editor(s) disclaim responsibility for any injury to people or property resulting from any ideas, methods, instructions or products referred to in the content. |
© 2023 by the authors. Licensee MDPI, Basel, Switzerland. This article is an open access article distributed under the terms and conditions of the Creative Commons Attribution (CC BY) license (https://creativecommons.org/licenses/by/4.0/).



